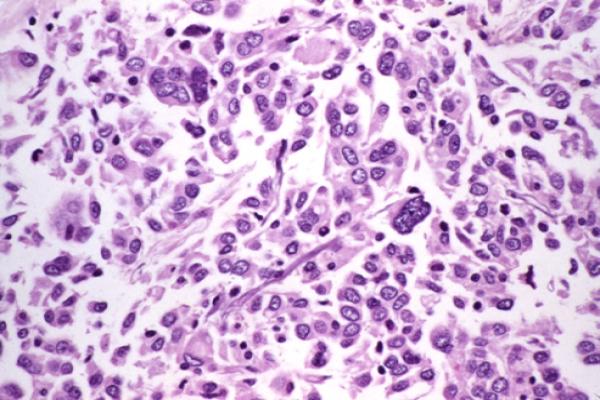

Is thyroid cancer curable?
Yes, in most cases, thyroid cancer is highly curable — especially when detected early. It is one of the few cancers with an excellent survival rate. Most patients, particularly those with the common types of thyroid cancer, go on to live full, healthy lives after treatment. With the right medical care and timely diagnosis, the chances of a complete cure are very high.
Introduction: Can Thyroid Cancer Be Cured?
When someone hears the words “thyroid cancer,” fear is the first reaction. But here is the good news — thyroid cancer is one of the most treatable and curable cancers in the world. Unlike many other cancers, most thyroid cancers grow slowly and respond very well to treatment.
At Hills Gastro & Onco Care, patients across Hyderabad and beyond receive expert care from Dr. MSS Keerthi, a Top Cancer Surgeon with over 17 years of experience in oncological surgery. With a patient-first approach and advanced treatment methods, Hills Gastro & Onco Care has helped hundreds of thyroid cancer patients recover successfully.
If you or a loved one has been diagnosed with thyroid cancer, understanding the condition is the first step toward recovery. This guide covers everything you need to know — from types to the thyroid cancer cure rate and available treatment options.
What Is Thyroid Cancer?
The thyroid is a small, butterfly-shaped gland located at the front of your neck. It produces hormones that regulate your metabolism, heart rate, and body temperature. When cells in the thyroid gland begin to grow abnormally and uncontrollably, it leads to thyroid cancer.
Types of Thyroid Cancer:
Thyroid cancer is not just one disease. There are different types, and each one behaves differently. Understanding the type helps doctors decide the best course of treatment.

Papillary Thyroid Cancer
This is the most common type, accounting for about 80% of all thyroid cancer cases. It grows slowly and rarely spreads beyond the thyroid and nearby lymph nodes. The cure rate is excellent.

Medullary Thyroid Cancer
This type develops from the C-cells of the thyroid gland. It can be inherited (familial) or occur randomly. It is more aggressive than papillary or follicular types but still manageable.

Follicular Thyroid Cancer
This is the second most common type. It can spread to the blood vessels and other organs, but is still highly treatable when diagnosed early.
Anaplastic Thyroid Cancer
This is the rarest and most aggressive form of thyroid cancer. It grows rapidly and is harder to treat. However, with advanced oncological care, treatment plans can still help manage the disease effectively.
Is Thyroid Cancer Curable?
Yes — thyroid cancer is highly curable, and here is why.
This section deserves a detailed explanation because it is the most important question patients and families ask.
Thyroid cancer is considered one of the most curable cancers in the world. The vast majority of patients — especially those with papillary and follicular thyroid cancer — achieve complete remission after treatment. Even in cases where cancer has spread to nearby lymph nodes, the outcomes remain very positive.
Here is what makes thyroid cancer so treatable:
- Slow Growth: Most thyroid cancers grow very slowly, giving doctors enough time to catch and treat them before they spread.
- High Sensitivity to Treatment: Thyroid cancer cells — especially differentiated types — respond exceptionally well to radioactive iodine therapy and surgery.
- Early Detection is Possible: Thyroid lumps are often noticed during routine check-ups or self-examination, which leads to early diagnosis.
- Low Recurrence in Most Types: Once treated, papillary and follicular thyroid cancers rarely come back.
Can thyroid cancer spread?
Yes, it can spread to lymph nodes or other parts of the body in advanced stages. However, even then, treatment options remain effective. Radioactive iodine can target thyroid cancer cells even after they have spread to other areas.
What about advanced thyroid cancer — is it still curable?
- In Stage 1 and Stage 2: Nearly 100% survival rate
- In Stage 3: Very high survival rate with the right treatment
- In Stage 4: Treatment can still control the disease and extend life significantly, especially with modern targeted therapies.
The bottom line is this — thyroid cancer, when treated at a quality oncological hospital in Hyderabad like Hills Gastro & Onco Care, has outstanding outcomes for the large majority of patients.
Key facts about thyroid cancer curability:
- Over 98% of patients with localised thyroid cancer survive beyond 5 years
- Papillary thyroid cancer has one of the best prognoses of any cancer
- Most patients return to a completely normal life after treatment
- Regular follow-up ensures long-term cancer-free living
Factors That Affect Cure Rate:
While thyroid cancer is largely curable, certain factors can influence the overall outcome and recovery.
- Type of Thyroid Cancer Papillary and follicular cancers have the highest cure rates. Medullary and anaplastic cancers require more aggressive treatment.
- Stage at Diagnosis The earlier the cancer is detected, the better the outcome. Stage 1 and Stage 2 thyroid cancers have near-perfect cure rates.
- Age of the Patient Younger patients generally respond better to treatment. However, older patients can also achieve excellent outcomes with proper care.
- Size of the Tumour Smaller tumours are easier to remove completely with surgery.
- Spread to Lymph Nodes or Other Organs Cancer that has spread requires more intensive treatment, but can still be managed effectively.
- Quality of Medical Care The expertise of the surgical team and the treatment centre plays a crucial role. Choosing a Top Cancer Surgeon and a trusted oncological hospital in Hyderabad significantly improves outcomes.
Survival Rate of Thyroid Cancer:
The survival rate of thyroid cancer is one of the most encouraging statistics in oncology.
These numbers reflect patients who received timely, proper cancer treatment in Hyderabad, India, and around the world. When managed at an experienced cancer care centre, these survival rates are achievable.
Regular monitoring after treatment — including TSH blood tests and imaging — ensures that any recurrence is caught and treated quickly.
Treatment Options for Thyroid Cancer at Hills Gastro & Onco Care:
At Hills Gastro & Onco Care, every patient receives a personalised treatment plan designed around their specific diagnosis, cancer type, stage, and overall health.
Dr. MSS Keerthi leads the oncology team with a combination of surgical precision and compassionate patient care. Here are the main treatment options available:
- Surgery (Thyroidectomy): The most common treatment for thyroid cancer. The surgeon removes part or all of the thyroid gland. Total thyroidectomy is recommended for most cases to ensure complete cancer removal.
- Radioactive Iodine Therapy (RAI): After surgery, radioactive iodine is used to destroy any remaining thyroid cells or cancer cells. This therapy is particularly effective for papillary and follicular thyroid cancers.
- Thyroid Hormone Therapy: After thyroid removal, patients take thyroid hormone medication (levothyroxine). This not only replaces the missing hormones but also suppresses TSH, which can stimulate cancer growth.
- External Beam Radiation Therapy: Used for cancers that do not respond to radioactive iodine, such as anaplastic thyroid cancer. Radiation is targeted precisely at the cancer cells.
- Chemotherapy: Typically used for aggressive forms of thyroid cancer in combination with other treatments.
- Targeted Drug Therapy: Modern targeted therapies are available for advanced thyroid cancers. These drugs specifically target the molecular signals that help cancer cells grow.
Hills Gastro & Onco Care is recognised as a leading oncological hospital in Hyderabad, offering comprehensive cancer treatment in Hyderabad, India, with the latest technology and highly experienced specialists.
Conclusion:
Thyroid cancer, while a serious diagnosis, is one of the most curable forms of cancer — especially with early detection and expert treatment. The thyroid cancer cure rate is among the highest of all cancers, and thousands of patients across India live healthy, cancer-free lives after treatment.
If you or a family member has been diagnosed with thyroid cancer or has noticed any symptoms, do not delay seeking medical advice. Early action saves lives.
Dr. MSS Keerthi and the dedicated team at Hills Gastro & Onco Care are here to guide you through every step of your cancer treatment journey — from diagnosis to recovery.
FAQs: Thyroid Cancer
Thyroid cancer is serious, but it is one of the least dangerous cancers compared to other types. Most thyroid cancers grow slowly and do not spread quickly. When detected early, it rarely becomes life-threatening. With timely diagnosis and proper treatment, the vast majority of patients recover completely and live a normal, healthy life. The key is not to ignore symptoms and to seek medical help as soon as possible.
In most cases, surgery is the primary and most effective treatment for thyroid cancer. However, in very small, low-risk thyroid cancers — particularly small papillary thyroid cancers — doctors may recommend active surveillance instead of immediate surgery. Additionally, treatments like radioactive iodine therapy and targeted drug therapy can be used alongside or after surgery. Whether surgery is needed or not depends entirely on the type, size, and stage of the cancer. Always consult a specialist for a personalised treatment plan.
Thyroid cancer is not always 100% curable in every case, but it comes very close. Papillary and follicular thyroid cancers — the most common types — have a survival rate of 98–99% when caught early. At Hills Gastro & Onco Care, Dr. MSS Keerthi and the expert oncology team provide advanced, personalised treatment that gives patients the best possible chance of a complete and lasting recovery. With the right care, most thyroid cancer patients go on to live fully cancer-free lives.